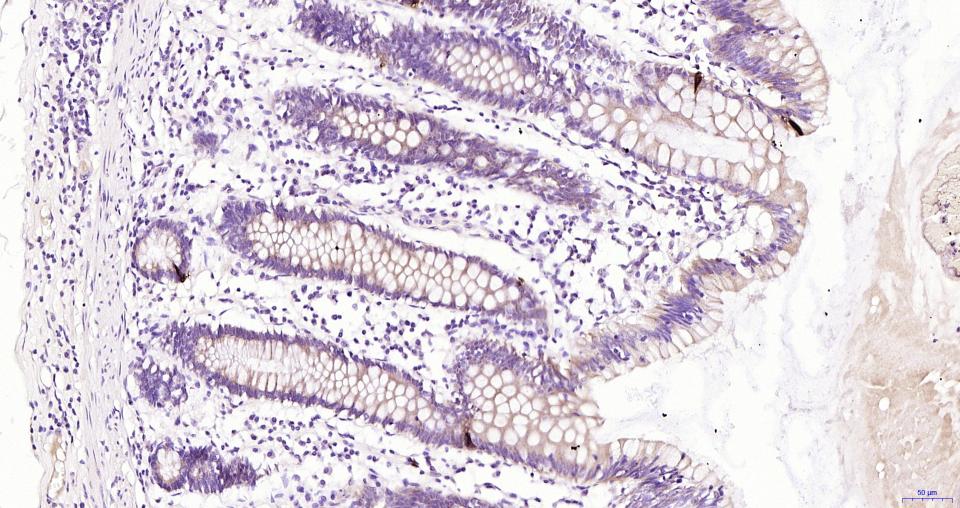
胰高血糖素重组兔单抗

Cancer > Cancer Metabolism > Metabolic signaling pathway > Integration of energy metabolism
Cancer > Tumor biomarkers > Hormones
Developmental Biology > Lineage specification > Endoderm
Metabolism > Pathways and Processes > Metabolic signaling pathways > Energy transfer pathways > Integration of energy
Metabolism > Types of disease > Cancer
产品组分及规格
|
编号 |
组分 |
规格 |
浓度 |
储存 |
|
1 |
PBS缓冲液(干粉) |
2 L×2 |
20x |
室温 |
|
2 |
抗原修复缓冲液 |
20 ml |
100x |
2-8℃ |
|
3 |
内源性过氧化物酶阻断剂 |
3 ml |
RTU |
2-8℃ |
|
4 |
封闭工作液 |
3 ml |
RTU |
2-8℃ |
|
5 |
一抗(Rat GLP-1 Mouse mAb) |
6 ml |
RTU |
2-8℃ |
|
6 |
二抗(HRP-Goat anti-Mouse IgG pAb) |
6 ml |
RTU |
2-8℃ |
|
7 |
DAB kit(20×)显色液 |
0.3 ml |
RTU |
-20℃ |
|
8 |
DAB kit(20×)稀释液 |
0.3 ml |
RTU |
-20℃ |
|
9 |
复染试剂 |
5 ml |
RTU |
室温 |
|
10 |
封片剂 |
5 ml |
RTU |
室温 |
|
11 |
对照切片(大鼠胰腺) |
1张 |
RTU |
室温 |
|
12 |
说明书 |
1份 |
|
|
背景
GCG is also known as GLP1, or Glucagon. Glucagon is a 29-amino acid pancreatic hormone that counteracts the glucose-lowering action of insulin by stimulating glycogenolysis and gluconeogenesis.It is mapped to 2q36-2q37. GLP1, also known as 7-37 for the codons of the preproglucagon molecule which encode it, renders pancreatic beta-cells 'glucose-competent' and may be useful in the treatment of noninsulin-dependent diabetes mellitus. Also, GLP1 is a potent insulin secretagogue.It plays a major role in the enteroinsular axis, accounting, for example, for the finding that plasma insulin levels accompanying oral intake of glucose are greater than those observed when glucose is given intravenously.
石蜡包埋组织的免疫组织化学方案
1. 脱蜡水化
石蜡切片置于新鲜二甲苯中浸泡脱蜡3次,每次15 min;依次置于不同浓度(100%、95%、90%、80%、70%)乙醇浸泡各5 min,再置于蒸馏水洗涤5 min,重复3次。
2. 抗原修复
沸水浴修复:将100×抗原修复缓冲液(试剂2)用蒸馏水稀释成1×抗原修复缓冲液,放入修复盒中并提前加热至95-100℃(注意盖好以防液体蒸发),然后将切片放入修复盒中,在沸水浴环境中保持外沸状态15 min,室温自然冷却;用PBS缓冲液(试剂1,将干粉溶解在2L蒸馏水中)清洗5 min,重复3次。
3. 阻断内源性过氧化物酶
用吸水纸吸去玻片上多余的液体,用免疫组化笔在组织周围画圈,加入2-4滴内源性过氧化物酶阻断剂(试剂3),室温下置于湿盒中孵育15 min,用PBS洗涤5 min,重复3次。
4. 血清封闭
用吸水纸吸去玻片上多余的液体,加入2-4滴封闭工作液(试剂4),置于湿盒内37℃封闭20 min,以减少非特异性染色。
5. 一抗孵育
用吸水纸吸去玻片上多余的液体,加入2-4滴大鼠GLP-1鼠单抗工作液(试剂5),置于湿盒中,4℃孵育过夜或37℃孵育1-2 h。
6. 复温
4℃孵育过夜后,室温下复温15 min (若在室温下孵育一抗,则直接进入下一步清洗);用PBS洗涤5 min,重复3次。
7. 二抗孵育
用吸水纸吸玻片上多余的液体,加入2-4滴HRP标记羊抗鼠IgG工作液(试剂6),置于湿盒中,37℃孵育1-2 h;用PBS洗涤5 min,重复3次。
8. 显色
用吸水纸吸去玻片上多余的液体,在每张切片上滴加约50 μL新配制的DAB工作液(试剂7:试剂8:PBS=1:1:18),作用3-5 min。显微镜下观察结果,达到合适的显色强度后,用蒸馏水冲洗切片以终止反应,用蒸馏水冲洗5 min,重复3次。
9. 复染
滴加适量复染试剂(试剂9)复染3-5 min,蒸馏水冲洗5 min,滴加盐酸酒精分化约30 s,蒸馏水洗涤5 min,重复2次。
10. 脱水封片
将玻片依次置于不同浓度(70%、80%、90%、95%、100%)乙醇,各5 min;然后置于新鲜二甲苯中浸泡脱蜡3次,每次15 min。用吸水纸吸去多余的二甲苯,滴加适量封片剂(试剂10)在组织上,将盖玻片盖在组织上,避免产生气泡。
注意事项
1. 建议检测时进行阴性及阳性对照,以提高实验的可靠性。
2. 本品中的配套试剂,请不要用其他生产商产品替换使用。
3. DAB为致癌物质,请采取必要的防范措施。
4. PBS洗涤液(试剂1)配制后在4℃可保存一周;抗原修复液(试剂2)及显色剂(试剂7和8)的工作液需每次实验时现用现配。
*5. 发表论文时引用本产品的写作建议 "IHC0109R, Bioss Antibodies"。引用示例: “Rat tissue sections using Rat GLP-1 IHC Kit (IHC0109R, Bioss Antibodies) were stained for GLP-1 according to the manufacturer's instructions.”

| 应用 | 已检合格种属 | 预测种属 | 推荐稀释比例 |
|---|---|---|---|
| WB | Mouse | Human, Rat | 1:500-2000 |
| IHC-P | Human, Mouse, Rat | 1:100-500 | |
| IHC-F | Human, Mouse, Rat | 1:100-500 | |
| IF | Human, Mouse, Rat | 1:100-500 |
交叉反应: Human, Mouse, Rat
暂无相关产品
暂无标记数据
暂无同靶标产品
暂无相关文献
暂无常见问题